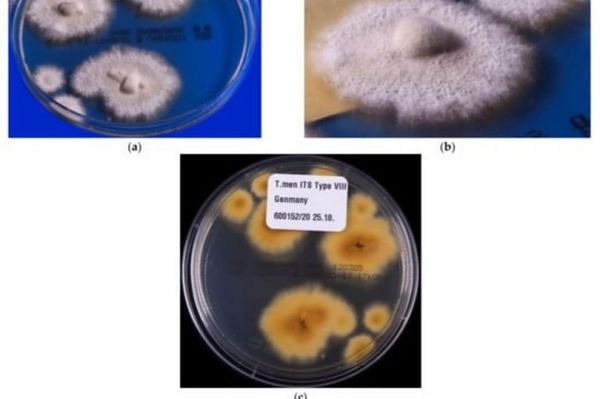

A drug-resistant 'super fungus' that attacks the groin and bum is spreading across Britain, experts have warned.
Cases of trichophyton indotineae - a drug-resistant fungal infectionthat causes unsightly, persistent skinlesions all over the body - are now soaring in the UK, despite being unheard of until a few years ago.
The infection, caused by a highly contagious fungus, is usually contracted through skin-to-skin contact with an infected person, but can also be spread through touching contaminated surfaces, household items orsexual contact. Most worryingly, it is often resistant to treatment - meaning sufferers can be holed up for weeks on end waiting for the rashes to go away.
- Many women are noticing hair loss - an expert gives tips on keeping hair healthy
- Nine prostate cancer symptoms everyone should know after David Cameron's diagnosis
First symptoms of T. indotineae infections usually show up as circular lesions in the the groin or buttocks, before spreading to other parts of the body. The fungus causes a severe and specific form of ringworm, a common infection known to doctors for centuries, but has developed resistance to most antifungal medicines.
Warning that people were now presenting with the disease at British hospitals, Professor Darius Armstrong-James, a fungal expert at Imperial College London, toldThe Sun: "It’s becoming a really big problem in the UK. "We don’t know how endemic, or pandemic, it will get here, but already, the growing frequency of new cases coming into hospitals is very concerning."
He said cases of trichophyton indotineae have surged by nearly 500% in the past three years, with the condition rarely diagnosed prior to this period. Until now, most cases have been concentrated on the Indian subcontinent, where the infection is said to be at near-epidemic levels after first being reported around 2014. The UK is among a number of countries seeing an increase in confirmed cases from what was previously a near-zero level, with the spread thought to be caused by increased international travel.
In May, the UK Health Security Agency (UKHSA) sent out an alert to medical professionals warning that people with persistent or recurrent ringworm infections or have failed standard treatment should be considered as potential T. indotineae cases.
Some cases in the UK have been linked to travel or contact with travellers from high-prevalence regions, including South Asia - though as many as 74% confirmed positive had no recent travel history, suggesting transmission is happening at a local level.
In the US, the first cases were confirmed in New York City in early 2023, after dermatologists reported seeing patients with severe ringworm that did not respond to standard oral antifungal treatments. Doctors in France and Germany have also reported a number of infections since 2021.
Contact to : xlf550402@gmail.com
Copyright © boyuanhulian 2020 - 2023. All Right Reserved.